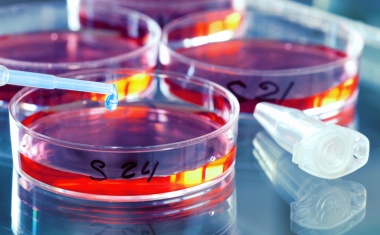
Photo

PRO-4-PRO Products for Professionals. Auf dieser Seite finden Sie Produkte, Lösungen und Dienstleistungen aus allen Bereichen des stationären Gesundheitswesen.


























Mit ihren Armaturen, Brausen und Duschsystemen gibt die Hansgrohe Group dem Wasser Form und Funktion – seit 1901. Das Unternehmen steht für langlebige Qualitätsprodukte, die bereits mit zahlreichen Designpreisen prämiert wurden. Dabei entstehen viele innovative Ideen und Produkte, die allen Menschen gleichermaßen einen Mehrwert bieten. Unabhängig davon, ob es sich um Kinder, Erwachsene oder Senioren handelt, um Menschen mit körperlichen Einschränkungen oder deren Pflegepersonal.

Nach über 45 Jahren, in vielen Auflagen und in mehreren Sprachen publizierten Buchausgaben, erscheint, neu konzipiert und auf dem neuesten Stand labordiagnostischer und klinischer Literatur, eine Internet-Ausgabe.



Siemens Healthineers stellt mit Ysio X.pree das weltweit erste intelligente Röntgensystem vor, das mit integrierter KI die Erstellung von Röntgenaufnahmen und damit die tägliche Routine optimiert.

Ein einfacher Sturz kann für ältere oder gehandicapte Menschen verheerende Auswirkungen haben.

